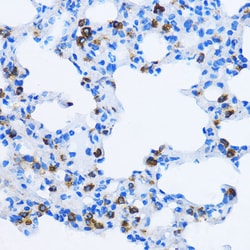
Invitrogen EEA1 Polyclonal Antibody 100 &mu;L | Buy Online | Invitrogen&trade; | Fisher Scientific

Learn More
Invitrogen™ EEA1 Polyclonal Antibody


Description
Immunogen sequence: LKAAVEQEKR NQQILKDQVK KEEEELKKEF IEKEAKLHSE IKEKEVGMKK HEENEAKLTM QITALNENLG TVKKEWQSSQ RRVSELEKQT DDLRGEIAVL EATVQNNQDE RRALLERCLK GEGEIEKLQT KVLELQRKLD NTTAAVQELG RENQSLQIKH TQALNRKWAE DNEVQNCMAC GKGFSVTVRR HHCRQCGNIF CAECSAKNAL TPSSKKPVRV CDACFNDLQG; Positive Samples: U-87MG, HT-1080, LO2, Mouse kidney, Mouse lung, Rat brain; Cellular Location: Cytoplasm, Early endosome membrane, Peripheral membrane protein.

Specifications
Specifications
| Antigen | EEA1 |
| Applications | ELISA, Immunohistochemistry (Paraffin), Western Blot |
| Classification | Polyclonal |
| Concentration | 1.13 mg/mL |
| Conjugate | Unconjugated |
| Formulation | PBS with 50% glycerol and 0.02% sodium azide; pH 7.3 |
| Gene | EEA1 |
| Gene Accession No. | Q15075, Q8BL66 |
| Gene Alias | A430109M19Rik; B230358H09Rik; Early endosome antigen 1; early endosome antigen 1, 162kD; early endosome-associated protein; EEA1; Endosome-associated protein p162; MST105; MSTP105; ZFYVE2; Zinc finger FYVE domain-containing protein 2 |
| Gene Symbols | EEA1 |
| Show More |
By clicking Submit, you acknowledge that you may be contacted by Fisher Scientific in regards to the feedback you have provided in this form. We will not share your information for any other purposes. All contact information provided shall also be maintained in accordance with our Privacy Policy.